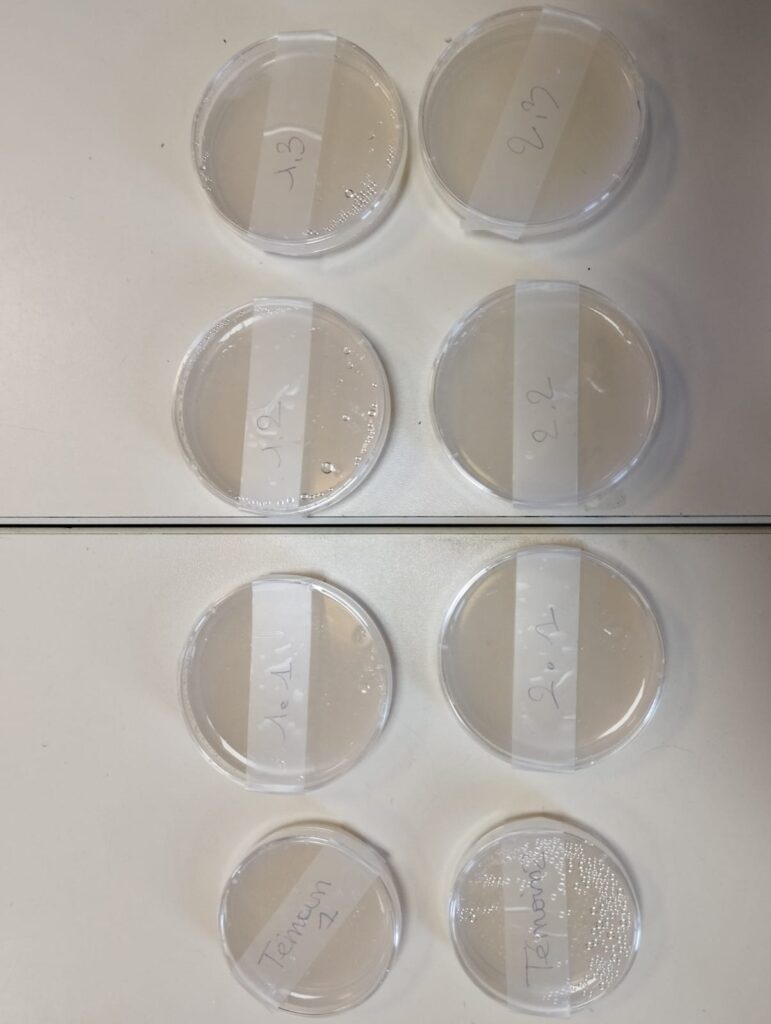

Atelier Hygiène et Lavage des mains avec Christine CHAPUT
Atelier autour des questions :
- Nos mains sont elles propres ?
- A quoi ça sert de se laver les mains ?
- Expériences et entrainement au lavage des mains











Atelier Hygiène et Lavage des mains avec Christine CHAPUT
Atelier autour des questions :